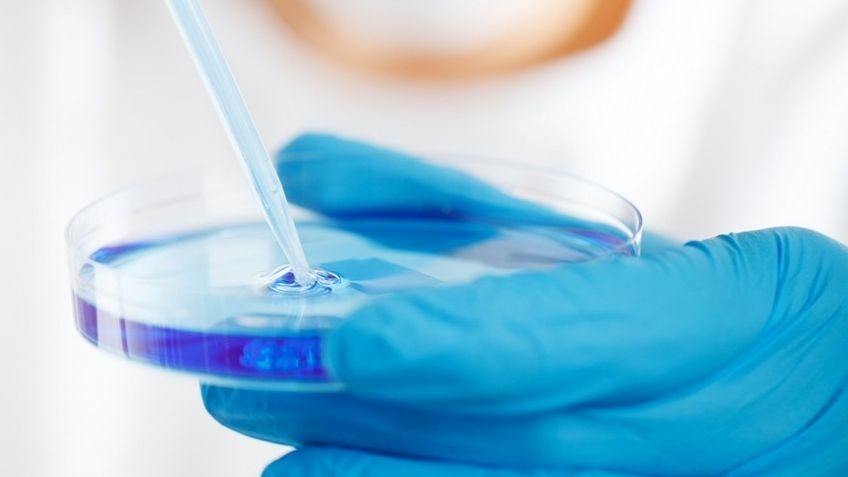
Hallan el cuerpo de una sirena en Japón; tras rigurosa investigación descifran qué es en realidad

Asakuchi, Japón.- En el siglo XVIII fue localizada una extraña criatura momificada en las profundidades del Océano Pacífico. Este curioso ser tenía la cola de un pez, el rostro de un simio (haciendo una perturbadora mueca) y unas manos de apariencia humana. Curiosamente, medía aproximadamente 30 centímetros y luego de un tiempo fue enviada al templo Enju-In en la ciudad Asakuchi, en Japón, donde se le conocía como un objeto sagrado.
Como era de esperarse, este ser despertó la curiosidad de la gente que sabía de su existencia, lo que daba paso a que muchos comenzaran a hablar sobre la existencia de animales que se quedaron en un punto medio de la evolución entre los peces y los humanos, por lo que comenzaron a comparar a este individuo con las sirenas occidentales, fue así que obtuvo su nombre como la sirena de Japón.
Luego de 300 años, un grupo de científicos de la Universidad de Ciencias y Artes de Kurashiki (KUSA) decidieron ponerle fin al misterio y comenzaron a investigar la identidad de la sirena japonesa, así que acudieron al templo de Enju, donde la pieza fue resguardada del siglo XVIII hasta el pasado mes de febrero del 2022 y, con la ayuda de un escáner, descubrieron que este ser no era otra cosa sino que una creación del humano.

Y es que, al hacerle las tomografías adecuadas descubrieron que no estaba rellena de huesos, sino que tenía algodón en su interior, sí como también portaba tela y papel. Aunque una parte de la muñeca sí tenía hueso y ésta era la mandíbula. Resulta ser que se trataba de un objeto conocido como ningyo (muñeca en japonés), que solían ser muy populares en los templos y museos del periodo Edo, en Japón.
De acuerdo con los expertos, este ningyo fue hecho con base en una cabeza de un simio real y un pez, mismos que fueron cortados a la mitad y posteriormente fueron rellenados y cocidos para que tuvieran el aspecto monstruoso de un youkai (demonio o espíritu japonés). Según el informe, la piel de la cola correspondería a un pez globo y a una especie de corvina, mientras que las uñas de los dedos pertenecían al cuerno de otro animal.
Fuentes: Tribuna